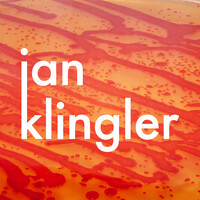
Jan Klingler Designs logo - Similar company to Volumeer

Company Details
- Founded
- 2023
- Industry
- Medical Equipment Manufacturing
- NAICS
-
Medical Equipment and Supplies ManufacturingSurgical and Medical Instrument ManufacturingSurgical Appliance and Supplies ManufacturingDental Equipment and Supplies ManufacturingOphthalmic Goods ManufacturingDental Laboratories
- Website
- http://www.volumeer.se
- Keywords
- Stockholm.